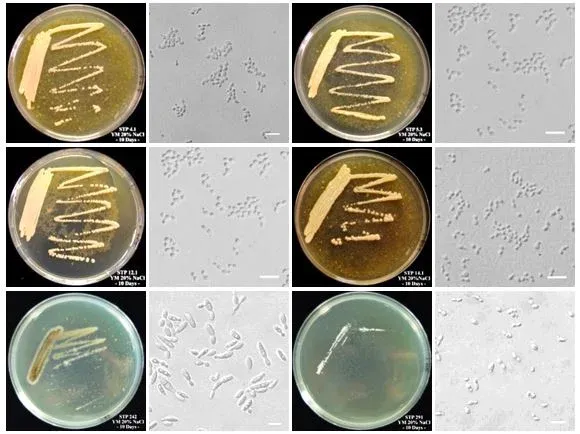

Sáng ngày 27 tháng 5, Bộ Công Thương tổ chức nghiệm thu nhiệm vụ**“Bảo tồn và lưu giữ nguồn gen vi sinh vật công nghiệp thực phẩm”** do PGS. TS Vũ Nguyên Thành – Phó Viện trưởng Viện Công nghiệp thực phẩm làm chủ nhiệm. Nhóm thực hiện đã bảo tồn an toàn 1.510 chủng giống trong sưu tập, trong đó duy trì bảo quản L-drying 1036 chủng, duy trì bảo quản trong ni tơ lỏng 1.059 chủng, bảo quản lạnh sâu 118 chủng và bảo quản cát 262 chủng. Bên cạnh đó, nhóm nghiên cứu đã hoàn thành kiểm tra sức sống của 116 chủng (40 chủng nấm men, 45 chủng nấm mốc, 33 chủng vi khuẩn, kiểm tra phân loại của 24 chủng nấm men) và kiểm tra hoạt lực của 43 chủng (20 chủng nấm men, 16 chủng nấm mốc, 7 chủng vi khuẩn).
Cùng ngày Bộ đã nghiệm thu nhiệm vụ “Thu thập và đánh giá nguồn gen vi sinh vật công nghiệp thực phẩm” do Thạc sỹ Nguyễn Thanh Thủy làm chủ nhiệm. Thực hiện nhiệm vụ được Bộ Công Thương giao, trong năm 2019, nhóm đã thu thập được 178 chủng vi sinh vật, trong đó đã phân lập 85 chủng nấm men chịu mặn sinh lipase và sinh protease, 73 chủng nấm mốc từ bánh men phục vụ lên men rượu gạo cùng với 20 chủng vi khuẩn để phục vụ ứng dụng sản xuất probiotics. Trong đó, đã đánh giá được 85 chủng nấm men chịu mặn bằng hình thái khuẩn lạc, PCR fingerprinting và định tên 11 chủng bằng giải trình tự rDNA. Bên cạnh đó, đánh giá khả năng sinh enzyme amylase với cơ chất là tinh bột của 73 chủng mốc bánh men cũng như khả năng thủy phân tinh bột của 25 chủng thuộc nhóm mốc khi có đường. Khả năng làm tan máu và kiểu hình lên men của 20 chủng vi khuẩn lactic cũng được thực hiện đánh giá đầy đủ và chi tiết
Hình ảnh khuẩn lạc và tế bào của các loài đã định tên: Candida sorbosivorans, Hyphopichia burtonii, Candida oceani, Candida etchellsii, Hortaea werneckii, Yamadazyma triangularis.
Chia sẻ bài viết
- Đoàn Cán Bộ Viện Hàn lâm Khoa học tỉnh Quảng Tây, Trung Quốc đến thăm và làm việc tại Viện Công Nghiệp Thực Phẩm24/04/2026
- Tham tán Kinh tế và Thương mại Israel đến Thăm và Làm việc tại Viện Công nghiệp thực phẩm21/04/2026
- Hội thảo Ứng dụng Vi sinh vật Biến đổi Gen trong Sản xuất Công nghiệp15/04/2026
- Tọa đàm Xây dựng Chương trình Khoa học Công nghệ và Đổi mới sáng tạo lĩnh vực Công Thương30/03/2026
- Bầu Cử Đại Biểu Quốc Hội Khóa XVI Và Đại Biểu HĐND Các Cấp Nhiệm Kỳ 2026-203112/03/2026
